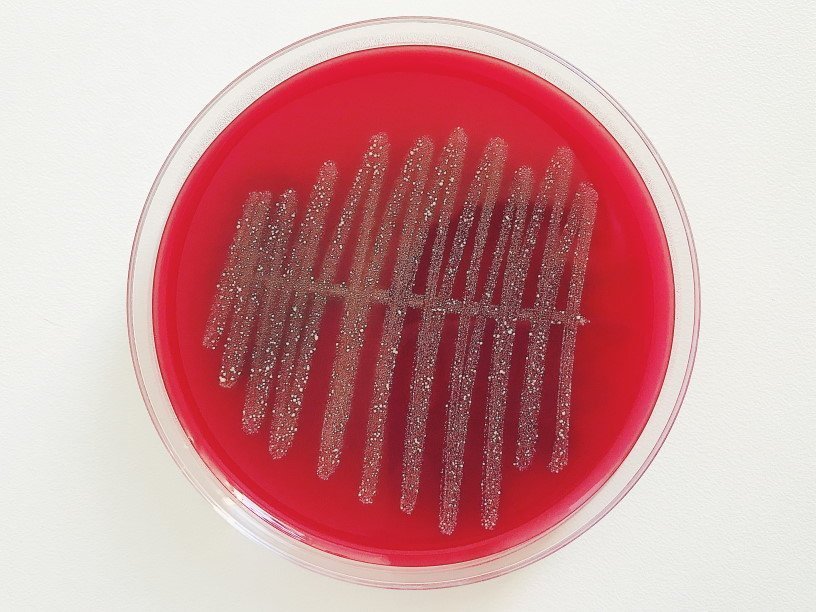

Екатерина Беленко: Промикробы: Кровавая среда
Фото: Екатерина Беленко
Фото: Екатерина Беленко Прочитав заголовок, вы подумали о дне недели (мои заметки выходят по средам) или о питательном субстрате для бактерий? Ужасно интересно было бы узнать. А правильного ответа нет, оба смысла подходят. В медицинской микробиологии кровь бывает по обе стороны баррикад — и как объект анализа, и как помощник в его проведении.
⠀
Посев крови — это гораздо более редкая вещь, чем бакпосев мочи или даже кала. Логично напрашивается вывод, что так происходит потому, что моча и кал сами покидают организм, а кровь надо насильно вытаскивать. Но дело не только в этом. Исследование крови на стерильность имеет смысл в случае проявления у пациента признаков сепсиса, а это не шутки. Это стойкая высокая температура на протяжении долгого времени. Заражение крови или септицемия может быть осложнением локального гнойного процесса из-за прорыва микроорганизма в кровяное русло — например, при пневмонии или остеомиелите. Среди всех отделений больницы основным поставщиком анализов крови на стерильность является реанимация, чтобы вы понимали масштаб септических процессов. У здорового человека кровь является стерильной, по крайней мере, по нынешним научным данным. Но даже у больного найти возбудителя довольно непросто. Поэтому в нашем арсенале специальные двухфазные питательные среды, а анализ гораздо более длительный, чем другие посевы, и может занимать неделю и даже больше.
Теперь про другую сторону медали — кровь на службе добра. Либо в простую питательную среду, либо в специальную, если это богатая лаборатория, добавляется кровь. Чтобы она не свернулась, проавтоклавированную основу агара необходимо охладить примерно до 45–40 градусов. Знаете же, что пятна крови надо стирать в холодной воде? Вот это про то же самое. Наверное, это будет признанием в нарушении стандартов процесса приготовления питательных сред, но мы в нашей лаборатории не суём градусник, а прикладываем колбу к щеке: если комфортно, то пора. Безошибочный метод. Если же поторопиться и добавить кровь раньше времени, получишь не красивые красные чашки Петри, а уродливые коричневые. Кровяной агар — универсальная питательная среда в медицинской микробиологии, незаменимая вещь. Она используется для культивирования прихотливых микроорганизмов и для первичной дифференциации по типу гемолиза, но о нём как-нибудь в другой раз. А на сегодня всё. Пойти, что ли, гематогенку съесть...
Смотрите также: Екатерина Беленко Промикробы: Ода кишечной микрофлоре Екатерина Беленко Промикробы: Грибы большие и маленькие Екатерина Беленко Промикробы: моча, окутанная мифами Екатерина Беленко Промикробы: Знакомьтесь, синегнойная палочка!